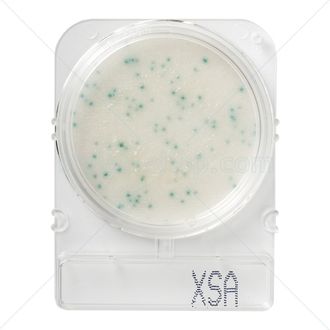

- Инструкция Compact_Dry_X-SA_Staph_Aureus74.4 кб, 29 апреля в 07:54
Подложки Compact Dry XSA (золотистый стафилококк)
Тест-система Compact Dry XSA предназначена для контроля гигиены на пищевых производствах и позволяет определить обсеменённость пищевых продуктов золотистым стафилококком. Определение контаминации пищевых продуктов данными бактериями имеет важное значение для производств, потому что бактерия вызывает большое количество заболеваний: от легких кожных до смертельно опасных, таких, как менингит, пневмония, остеомиелит, абсцессы, а также является одним из самых распространённых возбудителей внутрибольничных инфекций.
Широкий спектр матриц – вода, жидкие пищевые продукты, твердые пищевые продукты, пробы, взятые с помощью тампонов – обеспечивает универсальность тест-системы, а легкая и быстрая пробоподготовка – возможность проводить множество анализов с минимальными усилиями. Тест-система прекрасно подходит для срочных и полевых исследований. Хорошая корреляция результатов с чашечным методом обеспечивает стабильность накапливаемых результатов. Широкий допустимый температурный диапазон (от +1 до +30 ˚С), большой срок годности (18 месяцев с даты изготовления) и компактность подложек обеспечивают максимальное удобство хранения.
Тест-система представляет собой пластину с сухой хлопковой тканью: она трансформируется в гель в течение нескольких секунд после внесения пробы. Нет необходимости перемешивания или разбавления после инокуляции: пробы автоматически диффундируют по подложке.
Стафилококк формирует синие колонии. Окрашивание зоны роста в равномерный голубой цвет свидетельствует о высокой концентрации бактерий в изначальной пробе. Для проведения повторного анализа необходимо разбавить пробу.
Набор содержит:
20 (40 или 100) индикаторных пластин с нанесённой хлопковой тканью на полистирольной подложке.
Время инкубации: 24 ± 2 часа
Температура инкубации: 35 ± 2˚С (АОАС), 37 ± 1˚С (NordVal, MicroVal)
Площадь зоны роста: 20 см². Для удобства подсчета колоний на обратной стороне чашки нанесена сетка 1х1 см
Производство сертифицировано по ISO 9001.
Купить Подложки Compact Dry XSA (золотистый стафилококк) можно в компании Агролаб и заказать доставку в следующие города: Абакан, Анадырь, Архангельск, Астрахань, Барнаул, Белгород, Биробиджан, Благовещенск, Брянск, Великий Новгород, Владивосток, Владикавказ, Владимир, Волгоград, Вологда, Воронеж, Горно-Алтайск, Грозный, Екатеринбург, Иваново, Ижевск, Иркутск, Йошкар-Ола, Казань, Калининград, Калуга, Кемерово, Киров, Кострома, Краснодар, Красноярск, Курган, Курск, Кызыл, Липецк, Магадан, Магас, Майкоп, Махачкала, Москва, Мурманск, Нальчик, Нарьян-Мар, Нижний Новгород, Новосибирск, Омск, Оренбург, Орёл, Пенза, Пермь, Петрозаводск, Петропавловск-Камчатский, Псков, Ростов-на-Дону, Рязань, города Республики Крым, Санкт-Петербург, Салехард, Самара, Саранск, Саратов, Севастополь, Симферополь, Смоленск, Ставрополь, Сыктывкар, Тамбов, Тверь, Томск, Тула, Тюмень, Улан-Удэ, Ульяновск, Уфа, Хабаровск, Ханты-Мансийск, Чебоксары, Челябинск, Черкесск, Чита, Элиста, Южно-Сахалинск, Якутск, Ялта, Ярославль и др.
Информация, представленная на сайте, не является публичной офертой.